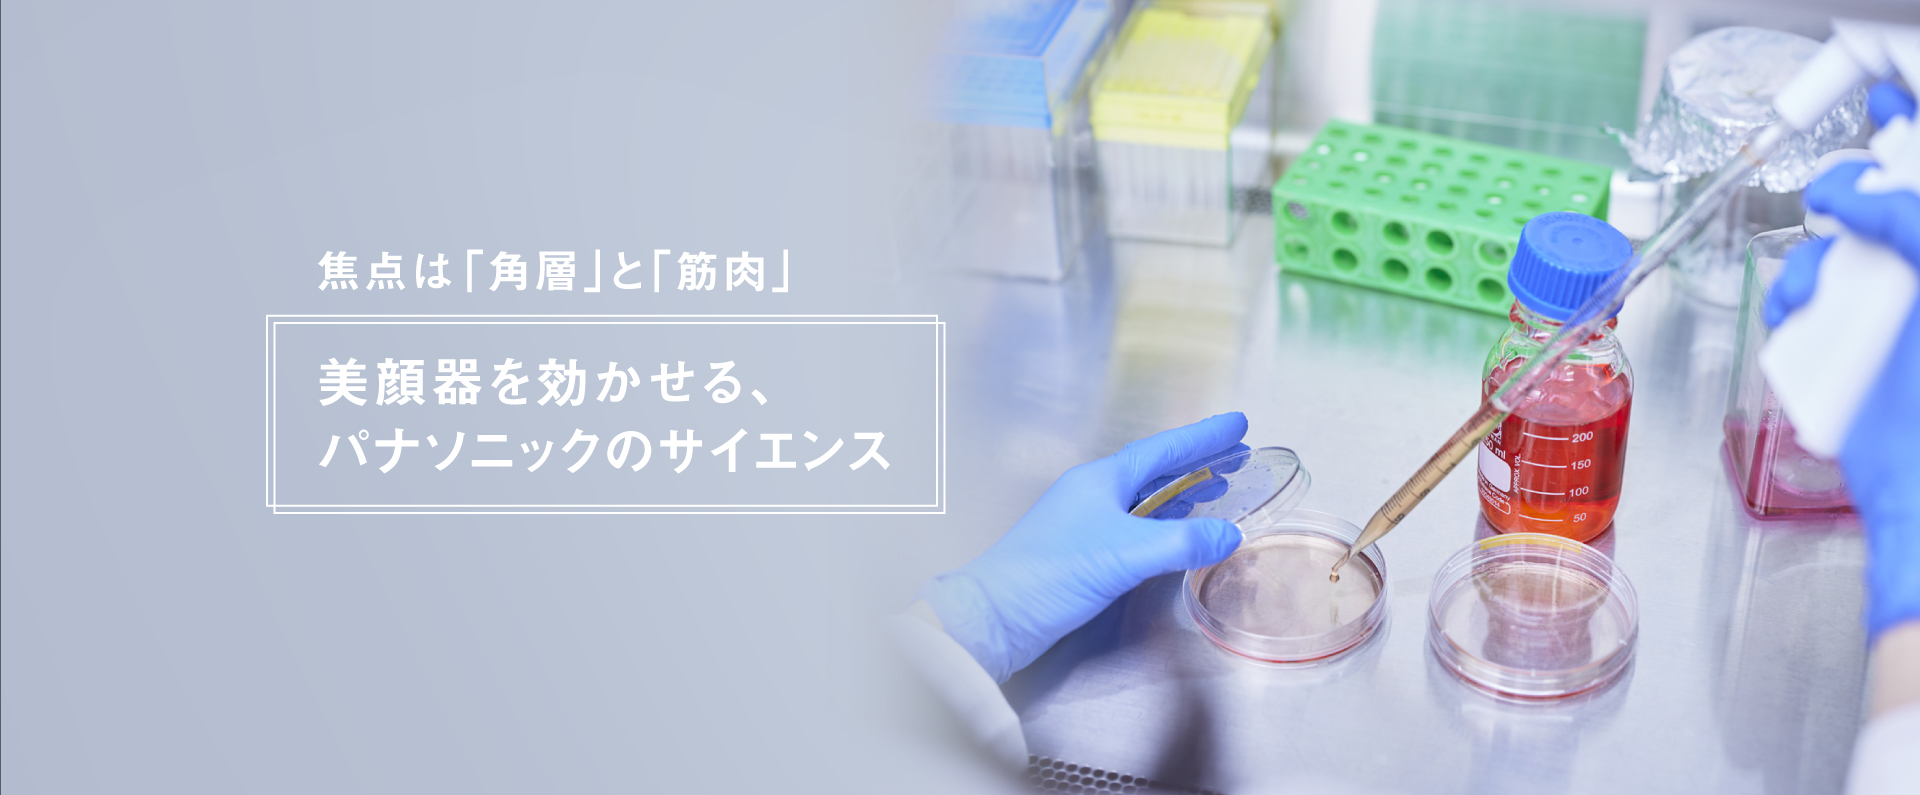
焦点は「角層」と「筋肉」,美顔器を効かせる、パナソニックのサイエンス

コンテンツ一覧
美顔器の種類が多くて迷っているあなたに。ぴったりの美顔器をご提案
使い方
サービス
NEW パナソニック 家電延長保証(商品登録タイプ)
ご購入いただいた対象商品をCLUB Panasonic上のマイ家電リストに商品登録し、当社の指定するメールマガジン「CLUB Panasonicニュース」の登録及びお申込みをいただくことでメーカー保証(1年)に加えて延長保証(2年)を無料で適用いたします。
特集
乾燥などの肌悩みにアプローチ 理想の肌に導く角層浸透スキンケア
しっかりスキンケアしたつもりでも悩みの多い「乾燥」。効果的に乾燥悩みへアプローチするためのヒントを美容皮膚科医の解説を交えてご紹介します。
「アドバンスドライン」って何が違うの?愛用者にインタビュー
アドバンスドラインを使用しているPanasonic Beauty 公式アンバサダー"社外美容部"のメンバーの皆さんにインタビューしました。
角質でも顔がくすむ!?肌に負担の少ないアイテムで「家での」ブライトケア※1
ダウンタイムのあるクリニック施術のハードルがあがりがちな夏におすすめな「家での」ブライトケア※1について、美容皮膚科医からのアドバイスを交えてご紹介します。
Q&A・レポート
※1 キメを整えて、肌を明るく見えるようにするケアのこと
※2 高分子浸透とは、ヒアルロン酸分子量5,000~10,000、コラーゲン分子量1,000~5,000を使用した浸透試験を実施